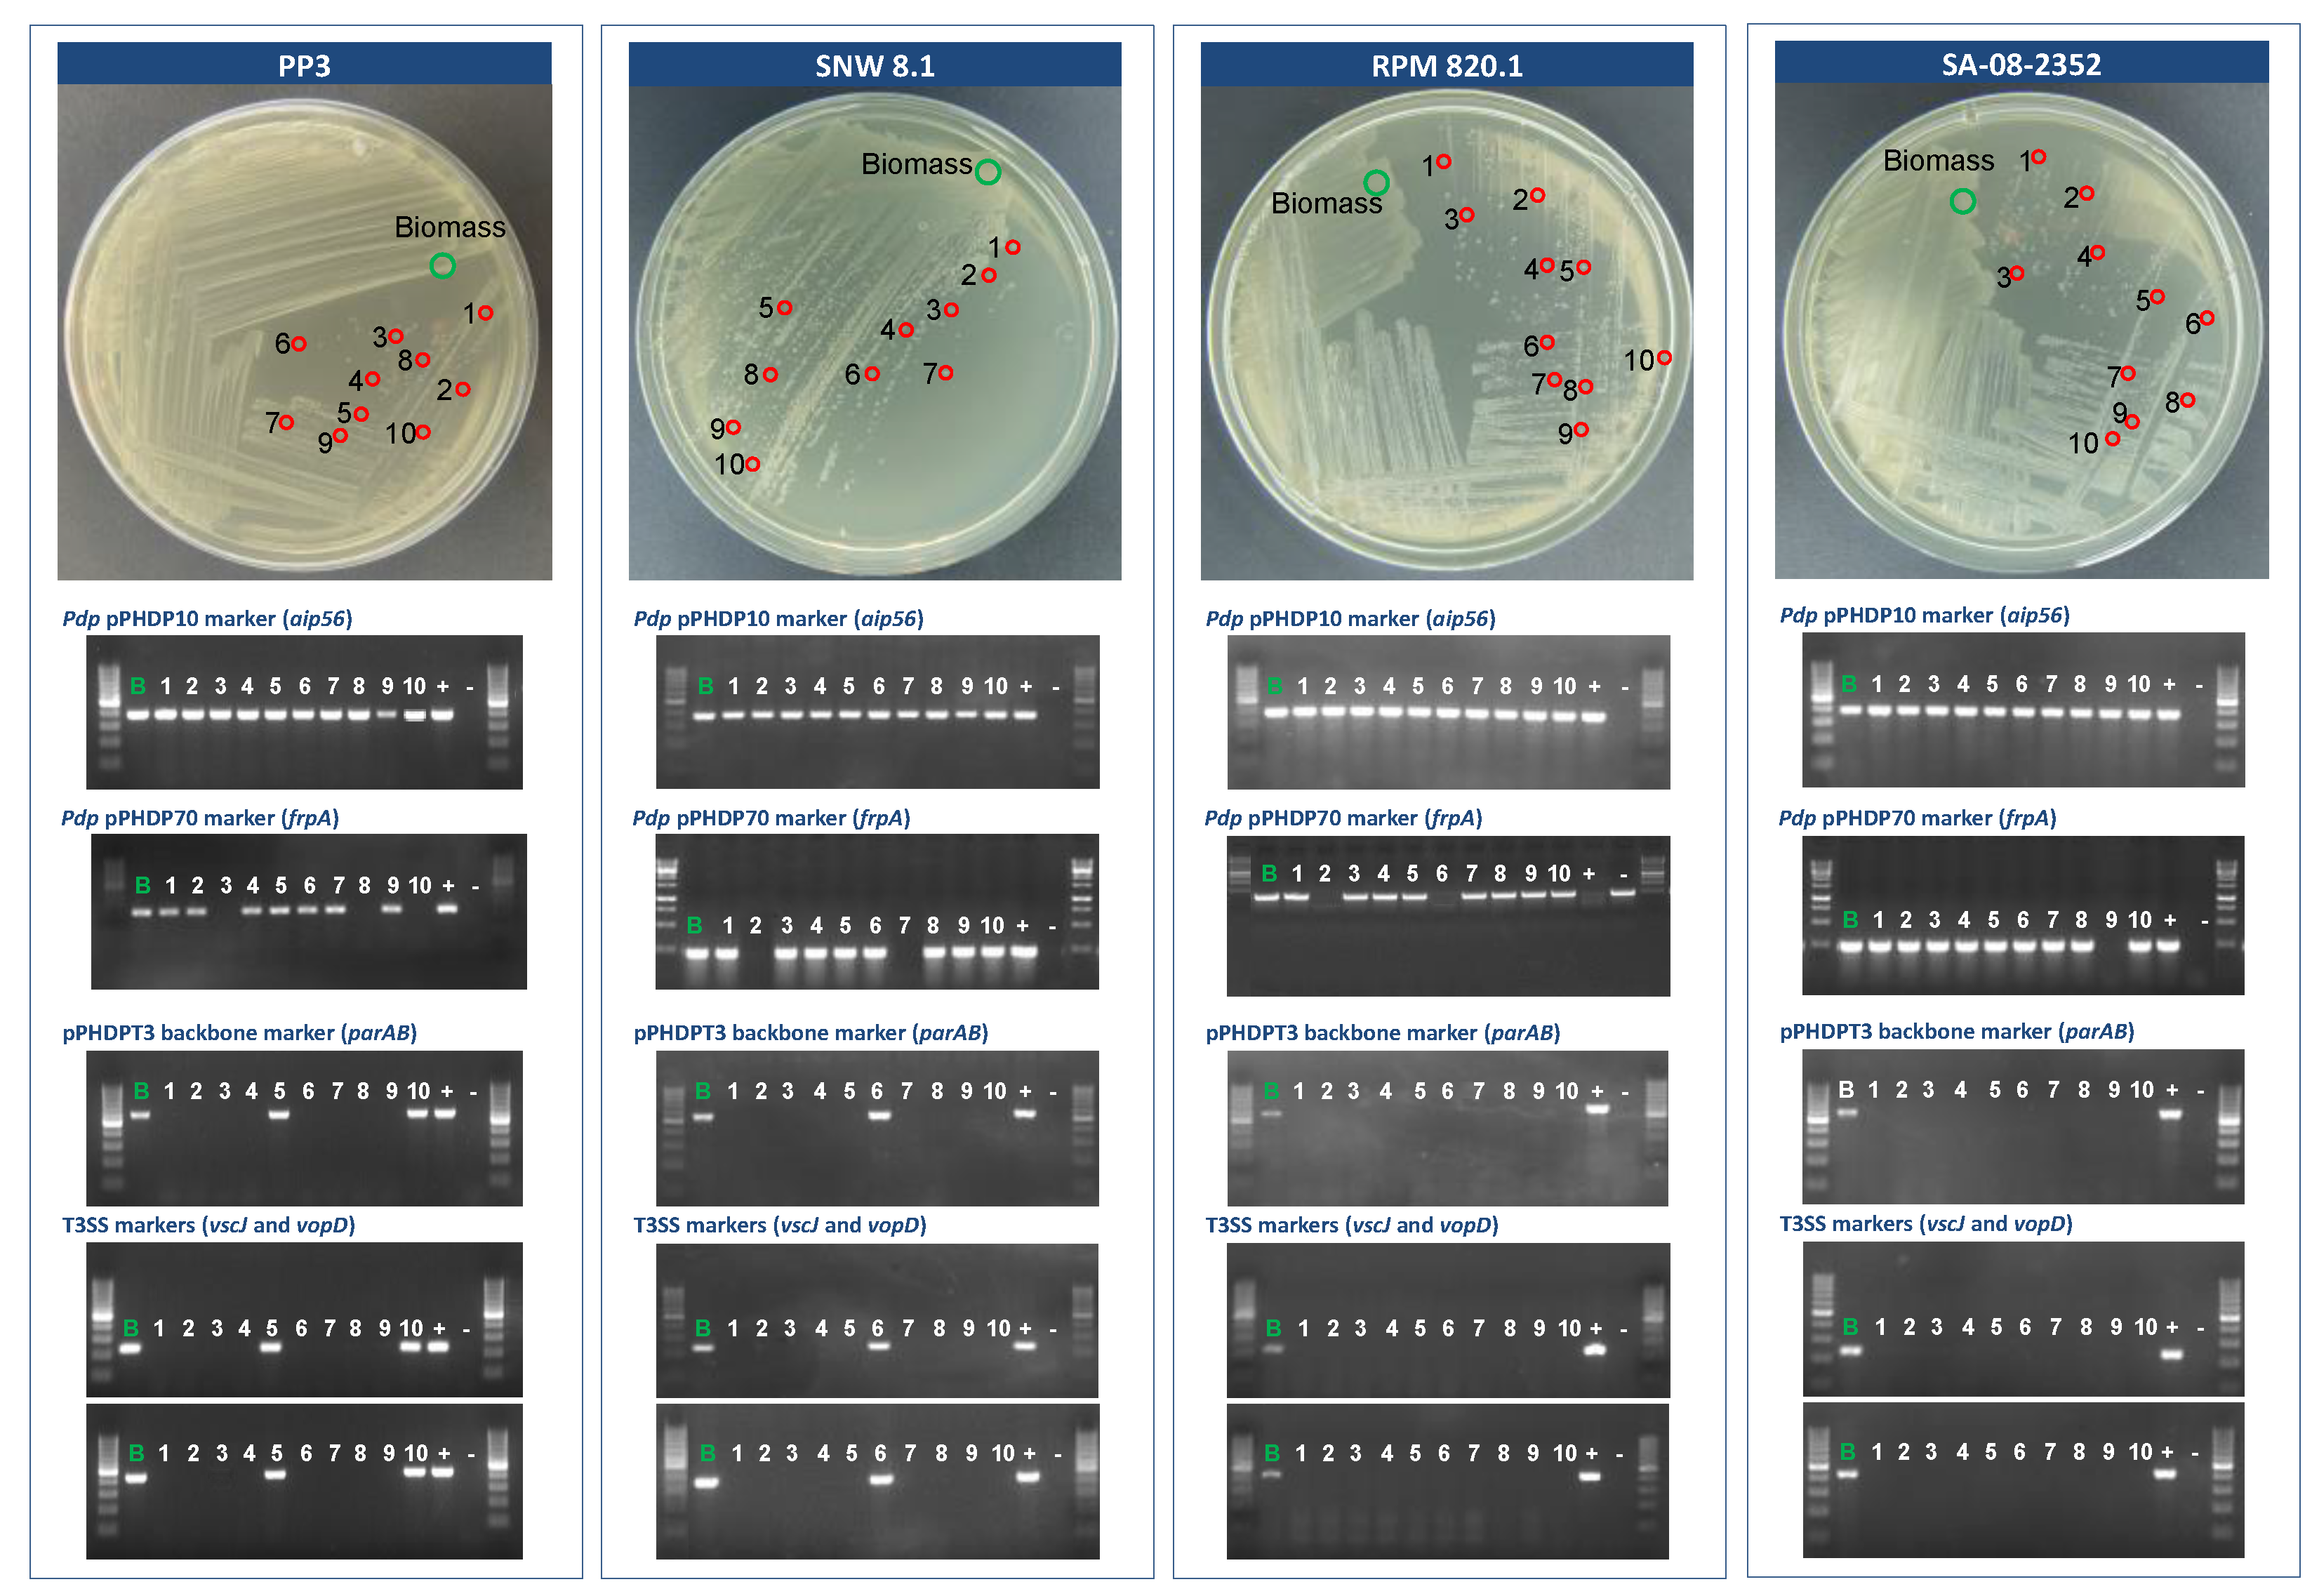

A Highly Unstable and Elusive Plasmid That Encodes the Type III Secretion System Is Necessary for Full Virulence in the Marine Fish Pathogen Photobacterium damselae subsp. piscicida
Abstract
:1. Introduction
2. Results
2.1. General Genome Features of Pdp PP3
2.2. Sequence Analysis of pPHDPT3, a Highly Unstable Plasmid That Encodes the T3SS Genes in Pdp
2.3. pPHDPT3 Is Highly Unstable and Undergoes Curing upon Cultivation in Laboratory
2.4. The Instability of pPHDPT3 Is a Generalized Feature of Pdp Isolates: T3SS Genes Are Highly Prevalent in Pdp Isolates and Undergo Loss during Cultivation
2.5. Tissues of Naturally-Infected Sea Bass Fish Suffering Photobacteriosis Test Positive for pPHDPT3 Genes, and These Become Lost following In Vitro Cultivation
2.6. pPHDPT3 Is Essential for Maximal Virulence in Pdp: Virulence for Fish Is Markedly Reduced in Cured Strains
2.7. pPHDPT3 Instability Impedes the Accurate Genetic Manipulation of the Plasmid
3. Discussion
4. Materials and Methods
4.1. Bacteria, Plasmids, and Media
4.2. DNA Sequencing, Annotation, and Comparative Genomics Analyses
4.3. PCR Amplifications
4.4. Phylogenetic Analysis
4.5. Processing of Diseased Fish Tissues for PCR and Pdp Cultivation
4.6. Selection of pPHDPT3-Cured Strains for Virulence Assays
4.7. Virulence Assays
4.8. Allelic-Exchange Mutagenesis of vcrD Gene Alleles of the T3SS
5. Conclusions
Supplementary Materials
Author Contributions
Funding
Institutional Review Board Statement
Data Availability Statement
Acknowledgments
Conflicts of Interest
References
- Snieszko, S.; Bullock, G.; Hollis, E.; Boone, J. Pasteurella sp. from an epizootic of white perch (Roccus americanus) in Chesapeake Bay tidewater areas. J. Bacteriol. 1964, 88, 1814–1815. [Google Scholar] [CrossRef] [PubMed] [Green Version]
- Romalde, J.L. Photobacterium damselae subsp. piscicida: An integrated view of a bacterial fish pathogen. Int. Microbiol. 2002, 5, 3–9. [Google Scholar] [CrossRef] [PubMed]
- Andreoni, F.; Magnani, M. Photobacteriosis: Prevention and diagnosis. J. Immunol. Res. 2014, 2014, 793817. [Google Scholar] [CrossRef] [PubMed] [Green Version]
- Håstein, T.; Gudding, R.; Evensen, O. Bacterial vaccines for fish—An update of the current situation worldwide. Dev. Biol. 2005, 121, 55–74. [Google Scholar]
- do Vale, A.; Marques, F.; Silva, M.T. Apoptosis of sea bass (Dicentrarchus labrax L.) neutrophils and macrophages induced by experimental infection with Photobacterium damselae subsp. piscicida. Fish Shellfish Immunol. 2003, 15, 129–144. [Google Scholar] [CrossRef]
- do Vale, A.; Silva, M.T.; dos Santos, N.M.; Nascimento, D.S.; Reis-Rodrigues, P.; Costa-Ramos, C.; Ellis, A.E.; Azevedo, J.E. AIP56, a novel plasmid-encoded virulence factor of Photobacterium damselae subsp. piscicida with apoptogenic activity against sea bass macrophages and neutrophils. Mol. Microbiol. 2005, 58, 1025–1038. [Google Scholar] [CrossRef]
- Silva, D.S.; Pereira, L.M.; Moreira, A.R.; Ferreira-da-Silva, F.; Brito, R.M.; Faria, T.Q.; Zornetta, I.; Montecucco, C.; Oliveira, P.; Azevedo, J.E.; et al. The apoptogenic toxin AIP56 is a metalloprotease A-B toxin that cleaves NF-κb P65. PLoS Pathog. 2013, 9, e1003128. [Google Scholar] [CrossRef] [Green Version]
- Pereira, L.M.; Pinto, R.D.; Silva, D.S.; Moreira, A.R.; Beitzinger, C.; Oliveira, P.; Sampaio, P.; Benz, R.; Azevedo, J.E.; dos Santos, N.M.; et al. Intracellular trafficking of AIP56, an NF-κB cleaving toxin from Photobacterium damselae subsp. piscicida. Infect. Immun. 2014, 82, 5270–5285. [Google Scholar] [CrossRef] [Green Version]
- do Vale, A.; Pereira, C.; Osorio, C.R.; dos Santos, N.M.S. The apoptogenic toxin AIP56 is secreted by the type II secretion system of Photobacterium damselae subsp. piscicida. Toxins 2017, 9, 368. [Google Scholar] [CrossRef] [Green Version]
- Abushattal, S.; Vences, A.; Osorio, C.R. A virulence gene typing scheme for Photobacterium damselae subsp. piscicida, the causative agent of fish photobacteriosis, reveals a high prevalence of plasmid-encoded virulence factors and of type III secretion system genes. Aquaculture 2020, 521, 735057. [Google Scholar] [CrossRef]
- Osorio, C.R.; Rivas, A.J.; Balado, M.; Fuentes-Monteverde, J.C.; Rodríguez, J.; Jiménez, C.; Lemos, M.L.; Waldor, M.K. A transmissible plasmid-borne pathogenicity island confers piscibactin biosynthesis in the fish pathogen Photobacterium damselae subsp. piscicida. Appl. Environ. Microbiol. 2015, 81, 5867–5879. [Google Scholar] [CrossRef] [PubMed] [Green Version]
- Balado, M.; Benzekri, H.; Labella, A.M.; Claros, M.G.; Manchado, M.; Borrego, J.J.; Osorio, C.R.; Lemos, M.L. Genomic analysis of the marine fish pathogen Photobacterium damselae subsp. piscicida: Insertion sequences proliferation is associated with chromosomal reorganisations and rampant gene decay. Infect. Genet. Evol. 2017, 54, 221–229. [Google Scholar] [CrossRef] [PubMed]
- Aoki, T.; Teru, Y.; Morimoto, N.; Kono, T.; Sakai, M.; Takano, T.; Hawke, J.P.; Fukuda, Y.; Takeyama, H.; Hikima, J.I. Complete genome sequence of Photobacterium damselae subsp. piscicida strain OT-51443 isolated from Yellowtail (Seriola quinqueradiata) in Japan. Genome Announc. 2017, 5, e00404-17. [Google Scholar] [CrossRef] [PubMed] [Green Version]
- Teru, Y.; Hikima, J.I.; Kono, T.; Sakai, M.; Takano, T.; Hawke, J.P.; Takeyama, H.; Aoki, T. Whole-genome sequence of Photobacterium damselae subsp. piscicida strain 91-197, isolated from hybrid striped bass (Morone sp.) in the United States. Genome Announc. 2017, 5, e00600-17. [Google Scholar] [CrossRef] [PubMed] [Green Version]
- Baseggio, L.; Silayeva, O.; Buller, N.; Landos, M.; Englestädter, J.; Barnes, A.C. Complete, closed and curated genome sequences of Photobacterium damselae subsp. piscicida isolates from Australia indicate mobilome-driven localized evolution and novel pathogenicity determinants. Microb. Genom. 2021, 7, 000562. [Google Scholar] [CrossRef]
- Osorio, C.R.; Vences, A.; Matanza, X.M.; Terceti, M.S. Photobacterium damselae subsp. damselae, a generalist pathogen with unique virulence factors and high genetic diversity. J. Bacteriol. 2018, 200, e00002-18. [Google Scholar] [CrossRef] [Green Version]
- Osorio, C.R. Photobacterium damselae: How horizontal gene transfer shaped two different pathogenic lifestyles in a marine bacterium. In Horizontal Gene Transfer; Villa, T.G., Viñas, M., Eds.; Springer Nature Switzerland AG: Cham, Switzerland, 2019; pp. 175–199. [Google Scholar]
- Abushattal, S.; Vences, A.; dos Santos, N.M.; do Vale, A.; Osorio, C.R. Draft genome sequences of Photobacterium damselae subsp. piscicida SNW-8.1 and PP3, two fish-isolated strains containing a type III secretion system. Microbiol. Res. Announc. 2019, 8, e00426-19. [Google Scholar] [CrossRef] [Green Version]
- Abrusci, P.; McDowell, M.A.; Lea, S.M.; Johnson, S. Building a secreting nanomachine: A structural overview of the T3SS. Curr. Opin. Struct. Biol. 2014, 25, 111–117. [Google Scholar] [CrossRef] [Green Version]
- Spreter, T.; Yip, C.K.; Sanowar, S.; André, I.; Kimbrough, T.G.; Vuckovic, M.; Pfuetzner, R.A.; Deng, W.; Angel, C.Y.; Finlay, B.B. A conserved structural motif mediates formation of the periplasmic rings in the type III secretion system. Nat. Struct. Mol. Biol. 2009, 16, 468–476. [Google Scholar] [CrossRef] [Green Version]
- Galán, J.E.; Wolf-Watz, H. Protein delivery into eukaryotic cells by type III secretion machines. Nature 2006, 444, 567–573. [Google Scholar] [CrossRef]
- Rahmatelahi, H.; El-Matbouli, M.; Menanteau-Ledouble, S. Delivering the pain: An overview of the type III secretion system with special consideration for aquatic pathogens. Vet. Res. 2021, 52, 146. [Google Scholar] [CrossRef] [PubMed]
- Makino, K.; Oshima, K.; Kurokawa, K.; Yokoyama, K.; Uda, T.; Tagomori, K.; Iijima, Y.; Najima, M.; Nakano, M.; Yamashita, A.; et al. Genome sequence of Vibrio parahaemolyticus: A pathogenic mechanism distinct from that of V. cholerae. Lancet 2003, 361, 743–749. [Google Scholar] [CrossRef]
- Zhao, Z.; Chen, C.; Hu, C.Q.; Ren, C.H.; Zhao, J.J.; Zhang, L.P.; Luo, P.; Wang, Q.B. The type III secretion system of Vibrio alginolyticus induces rapid apoptosis, cell rounding and osmotic lysis of fish cells. Microbiology 2010, 156, 2864–2872. [Google Scholar] [CrossRef] [PubMed] [Green Version]
- Henke, J.M.; Bassler, B.L. Quorum sensing regulates type III secretion in Vibrio harveyi and Vibrio parahaemolyticus. J. Bacteriol. 2004, 186, 3794–3805. [Google Scholar] [CrossRef] [Green Version]
- Luo, H.; Gao, F. DoriC 10.0: An updated database of replication origins in prokaryotic genomes including chromosomes and plasmids. Nucleic Acids Res. 2019, 47, D74–D77. [Google Scholar] [CrossRef] [Green Version]
- Le Roux, F.; Davis, B.M.; Waldor, M.K. Conserved small RNAs govern replication and incompatibility of a diverse new plasmid family from marine bacteria. Nucleic Acids Res. 2011, 39, 1004–1013. [Google Scholar] [CrossRef] [Green Version]
- Burkinshaw, B.J.; Strynadka, N.C. Assembly and structure of the T3SS. Biochim. Biophys. Acta 2014, 1843, 1649–1663. [Google Scholar] [CrossRef] [Green Version]
- Vences, A.; Rivas, A.J.; Lemos, M.L.; Husmann, M.; Osorio, C.R. Chromosome-encoded hemolysin, phospholipase, and collagenase in plasmidless isolates of Photobacterium damselae subsp. damselae contribute to virulence for fish. Appl. Environ. Microbiol. 2017, 83, e00401-17. [Google Scholar] [CrossRef] [Green Version]
- Balado, M.; Lemos, M.L.; Osorio, C.R. Genetic characterization of pPHDP60, a novel conjugative plasmid from the marine fish pathogen Photobacterium damselae subsp. piscicida. Plasmid 2013, 70, 154–159. [Google Scholar] [CrossRef]
- Osorio, C.R. T3SS effectors in Vibrios: Homology in sequence, diversity in biological functions? Virulence 2018, 9, 721–723. [Google Scholar] [CrossRef]
- Liu, P.C.; Lin, J.Y.; Lee, K.K. Virulence of Photobacterium damselae subsp. piscicida in cultured cobia Rachycentron canadum. J. Basic Microbiol. 2003, 43, 499–507. [Google Scholar] [CrossRef] [PubMed]
- Essam, H.M.; Abdellrazeq, G.S.; Tayel, S.I.; Torky, H.A.; Fadel, A.H. Pathogenesis of Photobacterium damselae subspecies infections in sea bass and sea bream. Microb. Pathog. 2016, 99, 41–50. [Google Scholar] [CrossRef] [PubMed]
- Costa, J.Z.; McCarthy, Ú.; Perez, O.; Ramos, E.; Rodriguez, M.; Monterroso, O.; Riera, R. Occurrence of Photobacterium damselae subsp. piscicida in sea-cage farmed meagre (Argyrosomus regius) in Tenerife, Canary Islands, Spain. Thalassas 2017, 33, 65–71. [Google Scholar] [CrossRef]
- Leu, M.; Wong, S.; Tay, Y.; Bandara, E.; Tsai, M. Infection of farmed sub-adult semicircle angelfish, Pomacanthus semicirculatus in Taiwan caused by Photobacterium damselae subsp. piscicida. Bull. Eur. Ass. Fish Pathol. 2019, 39, 137–144. [Google Scholar]
- Pham, T.H.; Cheng, T.C.; Wang, P.C.; Chen, S.C. Genotypic diversity, and molecular and pathogenic characterization of Photobacterium damselae subsp. piscicida isolated from different fish species in Taiwan. J. Fish Dis. 2020, 43, 757–774. [Google Scholar] [CrossRef]
- Shimada, M.T.; Yunis-Aguinaga, J.; Cueva-Quiroz, V.A.; Engracia, J.R.; Mourino, J.L.P.; Claudiano, G.S.; Moraes, F.R.; Moraes, J.R.E. Isolation and characterization of pathology in case of massive mortality by Photobacterium damselae subsp. piscicida in Rachycentron canadum. Biosci. J. 2020, 36, 1732–1741. [Google Scholar] [CrossRef]
- Chattoraj, D.K. Control of plasmid DNA replication by iterons: No longer paradoxical. Mol. Microbiol. 2000, 37, 467–476. [Google Scholar] [CrossRef]
- Brantl, S. Antisense RNAs in plasmids: Control of replication and maintenance. Plasmid 2002, 48, 165–173. [Google Scholar] [CrossRef]
- Gerdes, K.; Howard, M.; Szardenings, F. Pushing and pulling in prokaryotic DNA segregation. Cell 2010, 141, 927–942. [Google Scholar] [CrossRef] [Green Version]
- Salje, J.; Gayathri, P.; Löwe, J. The ParMRC system: Molecular mechanisms of plasmid segregation by actin-like filaments. Nat. Rev. Microbiol. 2010, 8, 683–692. [Google Scholar] [CrossRef]
- Hayes, F. Toxins-antitoxins: Plasmid maintenance, programmed cell death, and cell cycle arrest. Science 2003, 301, 1496–1499. [Google Scholar] [CrossRef] [PubMed]
- Schuster, C.F.; Bertram, R. Toxin-antitoxin systems are ubiquitous and versatile modulators of prokaryotic cell fate. FEMS Microbiol. Lett. 2013, 340, 73–85. [Google Scholar] [CrossRef] [PubMed]
- Lau, B.T.C.; Malkus, P.; Paulsson, J. New quantitative methods for measuring plasmid loss rates reveal unexpected stability. Plasmid 2013, 70, 353–361. [Google Scholar] [CrossRef] [PubMed] [Green Version]
- Sheppard, A.E.; Nakad, R.; Saebelfeld, M.; Masche, A.C.; Dierking, K.; Schulenburg, H. High instability of a nematicidal Cry toxin plasmid in Bacillus thuringiensis. J. Invertebr. Pathol. 2016, 133, 34–40. [Google Scholar] [CrossRef]
- Stuber, K.; Burr, S.E.; Braun, M.; Wahli, T.; Frey, J. Type III secretion genes in Aeromonas salmonicida subsp. salmonicida are located on a large thermolabile virulence plasmid. J. Clin. Microbiol. 2003, 41, 3854–3856. [Google Scholar] [CrossRef] [Green Version]
- Tanaka, K.H.; Vincent, A.T.; Emond-Rheault, J.-G.; Adamczuk, M.; Frenette, M.; Charette, S.J. Plasmid composition in Aeromonas salmonicida subsp. salmonicida 01-B526 unravels unsuspected type three secretion system loss patterns. BMC Genom. 2017, 18, 528. [Google Scholar] [CrossRef] [Green Version]
- Buchrieser, C.; Glaser, P.; Rusniok, C.; Nedjari, H.; D’Hauteville, H.; Kunst, F.; Sansonetti, P.; Parsot, C. The virulence plasmid pWR100 and the repertoire of proteins secreted by the type III secretion apparatus of Shigella flexneri. Mol. Microbiol. 2000, 38, 760–771. [Google Scholar] [CrossRef]
- Venkatesan, M.M.; Goldberg, M.B.; Rose, D.J.; Grotbeck, E.J.; Burland, V.; Blattner, F.R. Complete DNA sequence and analysis of the large virulence plasmid of Shigella flexneri. Infect. Immun. 2001, 69, 3271–3285. [Google Scholar] [CrossRef] [Green Version]
- Sayeed, S.; Reaves, L.; Radnedge, L.; Austin, S. The stability region of the large virulence plasmid of Shigella flexneri encodes an efficient postsegregational killing system. J. Bacteriol. 2000, 182, 2416–2421. [Google Scholar] [CrossRef] [Green Version]
- Sasakawa, C.; Kamata, K.; Sakai, T.; Murayama, S.Y.; Makino, S.; Yoshikawa, M. Molecular alteration of the 140-megadalton plasmid associated with loss of virulence and Congo red binding activity in Shigella flexneri. Infect. Immun. 1986, 51, 470–475. [Google Scholar] [CrossRef] [Green Version]
- McVicker, G.; Tang, C.M. Deletion of toxin-antitoxin systems in the evolution of Shigella sonnei as a host-adapted pathogen. Nat. Microbiol. 2016, 2, 16204. [Google Scholar] [CrossRef] [PubMed]
- Pilla, G.; McVicker, G.; Tang, C.M. Genetic plasticity of the Shigella virulence plasmid is mediated by intra-and inter-molecular events between insertion sequences. PLoS Genet. 2017, 13, e1007014. [Google Scholar] [CrossRef] [PubMed]
- Kawakami, H.; Suzukawa, K.; Yamashita, H.; Kohno, Y.; Kono, T.; Sakai, M. Mass mortality of wild largescale blackfish Girella punctata caused by Photobacterium damsela subsp. piscicida. Fish Pathol. 1999, 34, 87–88. [Google Scholar]
- Magariños, B.; Romalde, J.L.; López-Romalde, S.; Moriñigo, M.A.; Toranzo, A.E. Pathobiological characterisation of Photobacterium damselae subsp. piscicida isolated from cultured sole (Solea senegalensis). Eur. Ass. Fish Pathol. 2003, 23, 183–190. [Google Scholar]
- Zorrilla, I.; Chabrillón, M.; Arijo, S.; Díaz-Rosales, P.; Martínez-Manzanares, E.; Balebona, M.C.; Moriñigo, M.A. Bacteria recovered from diseased cultured gilthead sea bream (Sparus aurata L.) in southwestern Spain. Aquaculture 2003, 218, 11–20. [Google Scholar] [CrossRef]
- Magariños, B.; Romalde, J.L.; Bandín, I.; Fouz, B.; Toranzo, A.E. Phenotypic, antigenic and molecular characterization of Pasteurella piscicida strains isolated from fish. Appl. Environ. Microbiol. 1992, 58, 3316–3322. [Google Scholar] [CrossRef] [Green Version]
- Hawke, J.P.; Thune, R.L.; Cooper, R.K.; Judice, E.; Kelly-Smith, M. Molecular and phenotypic characterization of strains of Photobacterium damselae subsp. piscicida isolated from hybrid striped bass cultured in Louisiana, USA. J. Aquat. Animal Health 2003, 15, 189–201. [Google Scholar] [CrossRef]
- Dacanay, A.; Knickle, L.; Solanky, K.S.; Boyd, J.M.; Walter, J.A.; Brown, L.L.; Johnson, S.C.; Reith, M. Contribution of the type III secretion system (TTSS) to virulence of Aeromonas salmonicida subsp. salmonicida. Microbiology 2006, 152, 1847–1856. [Google Scholar] [CrossRef] [Green Version]
- Guan, K.L.; Dixon, J.E. Protein tyrosine phosphatase activity of an essential virulence determinant in Yersinia. Science 1990, 249, 553–556. [Google Scholar] [CrossRef]
- Bliska, J.B.; Guan, K.L.; Dixon, J.E.; Falkow, S. Tyrosine phosphate hydrolysis of host proteins by an essential Yersinia virulence determinant. Proc. Natl. Acad. Sci. USA 1991, 88, 1187–1191. [Google Scholar] [CrossRef] [Green Version]
- Shaban, L.; Nguyen, G.T.; Mecsas-Faxon, B.D.; Swanson, K.D.; Tan, S.; Mecsas, J. Yersinia pseudotuberculosis YopH targets SKAP2-dependent and independent signaling pathways to block neutrophil antimicrobial mechanisms during infection. PLoS Pathog. 2020, 16, e1008576. [Google Scholar] [CrossRef] [PubMed]
- Lan, R.; Reeves, P.R. Escherichia coli in disguise: Molecular origins of Shigella. Microbes Infect. 2002, 4, 1125–1132. [Google Scholar] [CrossRef]
- Herrero, M.; de Lorenzo, V.; Timmis, K.N. Transposon vectors containing non-antibiotic resistance selection markers for cloning and stable chromosomal insertion of foreign genes in gram-negative bacteria. J. Bacteriol. 1990, 172, 6557–6567. [Google Scholar] [CrossRef] [Green Version]
- Le Roux, F.; Binesse, J.; Saulnier, D.; Mazel, D. Construction of a Vibrio splendidus mutant lacking the metalloprotease gene vsm by use of a novel counterselectable suicide vector. Appl. Environ. Microbiol. 2007, 73, 777–784. [Google Scholar] [CrossRef] [PubMed] [Green Version]
- Mouriño, S.; Osorio, C.R.; Lemos, M.L. Characterization of heme uptake cluster genes in the fish pathogen Vibrio anguillarum. J. Bacteriol. 2004, 186, 6159–6167. [Google Scholar] [CrossRef] [PubMed] [Green Version]
- Datsenko, K.A.; Wanner, B.L. One-step inactivation of chromosomal genes in Escherichia coli K-12 using PCR products. Proc. Natl. Acad. Sci. USA 2000, 97, 6640–6645. [Google Scholar] [CrossRef] [Green Version]
- Kolmogorov, M.; Yuan, J.; Lin, Y.; Pevzner, P.A. Assembly of long, error-prone reads using repeat graphs. Nat. Biotechnol. 2019, 37, 540–546. [Google Scholar] [CrossRef]
- Tatusova, T.; DiCuccio, M.; Badretdin, A.; Chetvernin, V.; Nawrocki, E.P.; Zaslavsky, L.; Lomsadze, A.; Pruitt, K.D.; Borodovsky, M.; Ostell, J. NCBI Prokaryotic Genome Annotation Pipeline. Nucleic Acids Res. 2016, 44, 6614–6624. [Google Scholar] [CrossRef]
- Aziz, R.K.; Bartels, D.; Best, A.A.; DeJongh, M.; Disz, T.; Edwards, R.A.; Formsma, K.; Gerdes, S.; Glass, E.M.; Kubal, M.; et al. The RAST Server: Rapid annotations using subsystems technology. BMC Genom. 2008, 9, 75. [Google Scholar] [CrossRef] [Green Version]
- Altschul, S.F.; Madden, T.L.; Schäffer, A.A.; Zhang, J.; Zhang, Z.; Miller, W.; Lipman, D.J. Gapped BLAST and PSI-BLAST: A new generation of protein database search programs. Nucleic Acids Res. 1997, 25, 3389–3402. [Google Scholar] [CrossRef] [Green Version]
- Grant, J.R.; Stothard, P. The CGView Server: A comparative genomics tool for circular genomes. Nucleic Acids Res. 2008, 36, W181–W184. [Google Scholar] [CrossRef] [PubMed]
- Sullivan, M.J.; Petty, N.K.; Beatson, S.A. Easyfig: A genome comparison visualizer. Bioinformatics 2011, 27, 1009–1010. [Google Scholar] [CrossRef] [PubMed]
- Darling, A.E.; Mau, B.; Perna, N.T. ProgressiveMauve: Multiple genome alignment with gene gain, loss and rearrangement. PLoS ONE 2010, 5, e11147. [Google Scholar] [CrossRef] [PubMed] [Green Version]
- Kumar, S.; Stecher, G.; Li, M.; Knyaz, C.; Tamura, K. MEGA X: Molecular Evolutionary Genetics Analysis across Computing Platforms. Mol. Biol. Evol. 2018, 35, 1547–1549. [Google Scholar] [CrossRef] [PubMed]
- Thompson, J.D.; Higgins, D.G.; Gibson, T.J. CLUSTAL W: Improving the sensitivity of progressive multiple sequence alignment through sequence weighting, position-specific gap penalties and weight matrix choice. Nucleic Acids Res. 1994, 22, 4673–4680. [Google Scholar] [CrossRef] [PubMed] [Green Version]
- Saitou, N.; Nei, M. The neighbor-joining method: A new method for reconstructing phylogenetic trees. Mol. Biol. Evol. 1987, 4, 406–425. [Google Scholar] [CrossRef]
- Zuckerkandl, E.; Pauling, L. Evolutionary divergence and convergence in proteins. In Evolving Genes and Proteins; Bryson, V., Vogel, H.J., Eds.; Academic Press: New York, NY, USA, 1965; pp. 97–166. [Google Scholar]

| PP3 Genome (PacBio) | ||
|---|---|---|
| GenBank Accession no. | SRHT02000000 | |
| Genome size (bp) | 4,918,480 | |
| % GC | 40.90% | |
| Genes (total) | 4868 | |
| CDSs (total) | 4687 | |
| Contigs | Accession no. | size (bp) |
| Chromosome I | SRHT02000009.1 | 3,184,080 |
| Chromosome II | SRHT02000005.1 | 1,164,185 |
| pPHDP10-like | SRHT02000004.1 | 8115 |
| pPHDP70-like | SRHT02000008.1 | 81,347 |
| pPHDPT3 | SRHT02000010.1 | 133,065 |
| pPHDP286 | SRHT02000006.1 | 286,884 |
| plasmid unnamed1 | SRHT02000003.1 | 25,333 |
| plasmid unnamed1 | SRHT02000002.1 | 9318 |
| plasmid unnamed1 | SRHT02000001.1 | 2958 |
| plasmid unnamed2 | SRHT02000007.1 | 23,195 |
| IS Family | Chromosome I | Chromosome II | pPHDP10 | pPHDP70 | pPHDPT3 | pPHDP286 |
|---|---|---|---|---|---|---|
| IS1-like element ISPda1 family transposase | 183 | 162 | 0 | 3 | 4 | 0 |
| IS1 family transposase | 53 | 29 | 0 | 0 | 0 | 0 |
| IS91 family transposase | 23 | 40 | 3 | 6 | 0 | 1 |
| IS3 family transposase | 17 | 24 | 0 | 1 | 2 | 1 |
| IS91-like element ISPda2 family transposase | 9 | 14 | 0 | 3 | 15 | 0 |
| IS4 family transposase | 4 | 7 | 1 | 0 | 0 | 0 |
| IS4-like element ISVsa5 family transposase | 0 | 0 | 0 | 0 | 0 | 8 |
| Transposase zinc-binding domain-containing protein | 3 | 3 | 1 | 3 | 0 | 0 |
| IS30 family transposase | 1 | 0 | 0 | 0 | 0 | 0 |
| IS6 family transposase | 1 | 0 | 0 | 0 | 6 | 0 |
| Heteromeric transposase endonuclease subunit TnsA | 1 | 0 | 0 | 0 | 0 | 0 |
| ISNCY family transposase | 1 | 0 | 0 | 0 | 0 | 1 |
| IS5/IS1182 family transposase | 0 | 0 | 0 | 0 | 4 | 0 |
| Tn3 family transposase | 0 | 0 | 0 | 0 | 2 | 0 |
| Tn3-like element ISKox2 family transposase | 0 | 0 | 0 | 0 | 0 | 1 |
| IS110 family transposase | 0 | 0 | 0 | 0 | 0 | 1 |
| IS256 family transposase | 0 | 0 | 0 | 0 | 0 | 1 |
| Unclassified transposase | 0 | 0 | 0 | 1 | 0 | 0 |
| Total | 296 | 279 | 5 | 17 | 33 | 14 |
| Strain | Fish | Location | Year | pPHDP10 | pPHDP70 | pPHDPT3 | |||
|---|---|---|---|---|---|---|---|---|---|
| aip56 | frpA | vscJ | yopN | vopD | vscQ | ||||
| ATCC17911 | Roccus americanus | USA | 1963 | + | − | − | − | − | − |
| MZS8001 | Seriola quinqueradiata | Japan | 1980 | − | − | + | + | + | + |
| EPOY 8803 II | Epinephelus akaara | Japan | 1988 | − | − | − | − | − | − |
| P3333 | Seriola quinqueradiata | Japan | 1990 | + | + | + | + | + | + |
| DI91 | Sparus aurata | Spain | 1990 | + | + | + | + | + | + |
| B51 | Dicentrarchus labrax | Spain | 1991 | + | + | + | + | + | + |
| ATLIT2 | Morone sp. | Israel | 1993 | + | + | − | − | − | − |
| O69E | Sparus aurata | Greece | 1994 | + | + | + | + | + | + |
| DS11 | Sparus aurata | Spain | 1995 | − | + | − | − | − | − |
| 619.1 | Sparus aurata | Portugal | 1996 | + | + | + | + | + | + |
| LgB53/02 | Solea senegalensis | Spain | 2001 | + | − | − | − | − | − |
| PC609.1 | Sparus aurata | Spain | 2002 | + | + | + | + | + | + |
| TW515/02 | Solea senegalensis | Spain | 2002 | + | + | + | + | + | + |
| PC813.1 | Sparus aurata | Spain | 2003 | + | + | + | + | + | + |
| PC715.1 | Sparus aurata | Spain | 2003 | + | + | − | − | − | − |
| ACC29.1 | Solea senegalensis | Portugal | 2004 | + | + | + | + | + | + |
| ACC71.1 | Solea senegalensis | Portugal | 2006 | + | + | + | + | + | + |
| ACC72.1 | Solea senegalensis | Portugal | 2006 | + | + | + | + | + | + |
| RPM 820.1 | Solea senegalensis | Spain | 2007 | + | + | + | + | + | + |
| AQV6.1 | Solea senegalensis | Portugal | 2007 | + | + | + | + | + | + |
| 357/08 | Argyrosomus regius | Spain | 2008 | + | + | + | + | + | + |
| SA-08-2352 | Mugil cephalus | France | 2008 | + | + | + | + | + | + |
| AQV22.1 | Sparus aurata | Portugal | 2008 | + | + | + | + | + | + |
| AQV28.1 | Dicentrarchus labrax | Portugal | 2008 | + | + | + | + | + | + |
| AQP8.1 | Sparus aurata | Portugal | 2009 | + | + | + | + | + | + |
| AQP19.1 | Dicentrarchus labrax | Portugal | 2009 | + | + | + | + | + | + |
| SA082369T | Scophthalmus maximus | France | 2009 | + | − | − | − | − | − |
| SNW8.1 | Salmo salar | Spain | 2014 | + | + | + | + | + | + |
| SNW13.1 | Salmo salar | Spain | 2014 | + | + | + | + | + | + |
| AQV67.1 | Dicentrarchus labrax | Portugal | 2015 | + | + | + | + | + | + |
| AQV69.1 | Solea senegalensis | Portugal | 2015 | + | + | + | + | + | + |
| Pdp-AVL1902 | Dicentrarchus labrax | Turkey (Aegean Sea) | 2019 | + | + | + | + | + | + |
| Pdp-AVL2001 | Dicentrarchus labrax | Spain (Mediterranean) | 2020 | + | + | + | + | + | + |
| Pdp-AVL2004 | Dicentrarchus labrax | Spain (Mediterranean) | 2020 | + | + | + | + | + | + |
| Pdp-AVL2005 | Dicentrarchus labrax | Spain (Mediterranean) | 2020 | + | + | + | + | + | + |
| Pdp-AVL2006 | Dicentrarchus labrax | Spain (Atlantic) | 2020 | + | + | + | + | + | + |
| Pdp-AVL2011 | Dicentrarchus labrax | Spain (Atlantic) | 2020 | + | + | + | + | + | + |
| Pdp-AVL2012 | Dicentrarchus labrax | Spain (Atlantic) | 2020 | + | + | + | + | + | + |
| Pdp-AVL2017 | Dicentrarchus labrax | Turkey (Aegean Sea) | 2020 | + | + | + | + | + | + |
| Pdp-AVL2101 | Dicentrarchus labrax | Spain (Mediterranean) | 2021 | + | + | + | + | + | + |
| Pdp-AVL2106 | Dicentrarchus labrax | Spain (Mediterranean) | 2021 | + | + | + | + | + | + |
| Pdp-AVL2107 | Dicentrarchus labrax | Spain (Mediterranean) | 2021 | + | + | + | + | + | + |
| Pdp-AVL2109 | Dicentrarchus labrax | Spain (Mediterranean) | 2021 | + | + | + | + | + | + |
| Pdp-AVL2111 | Dicentrarchus labrax | Spain (Mediterranean) | 2021 | + | + | + | + | + | + |
| Pdp-AVL2112 | Dicentrarchus labrax | Spain (Mediterranean) | 2021 | + | + | + | + | + | + |
| Pdp-AVL2113 | Dicentrarchus labrax | Spain (Atlantic) | 2021 | + | + | + | + | + | + |
| Pdp-AVL2114 | Dicentrarchus labrax | Spain (Atlantic) | 2021 | + | + | + | + | + | + |
| Pdp-AVL2115 | Dicentrarchus labrax | Spain (Atlantic) | 2021 | + | + | + | + | + | + |
| Pdp-AVL2122 | Dicentrarchus labrax | Turkey (Aegean Sea) | 2021 | + | + | + | + | + | + |
| Pdp-AVL2134 | Dicentrarchus labrax | Greece (Aegean Sea) | 2021 | + | + | + | + | + | + |
| Pdp-AVL2135 | Dicentrarchus labrax | Greece (Aegean Sea) | 2021 | + | + | + | + | + | + |
| Strain or Plasmid | Description | Reference/Source |
|---|---|---|
| P. damselae subsp. piscicida | ||
| PP3 | Diseased Seriola quinqueradiata, Japan | [18] |
| SNW 8.1 | Diseased Salmo salar, Spain | [18] |
| DI21 | Diseased Sparus aurata, Spain | [57] |
| RPM 820.1 | Diseased Solea senegalensis, Spain | [10] |
| SA-08-2352 | Diseased Mugil cephalus, France | [10] |
| AVL_J231 | Diseased Dicentrarchus labrax, Spain | This study |
| AVL_J231CRD | AVL_J231 cured of pPHDPT3 | This study |
| AVL_J331 | Diseased Dicentrarchus labrax, Spain | This study |
| AVL_J331CRD | AVL_J331 cured of pPHDPT3 | This study |
| SSS256 | PP3 ∆vcrD1::cat | This study |
| SSS325 | PP3 ∆vcrD2::cat | This study |
| SSS299 | PP3 ∆vcrD1::cat ∆vcrD2::kan | This study |
| SSS260 | PP3 cured of pPHDPT3 | This study |
| Escherichia coli | ||
| DH5α | Cloning strain | Laboratory stock |
| S17-1-λpir | RP4-2 (Kan::Tn7,Tc::Mu-1) pro-82 λpir recA1 endA1 thiE1 hsdR17 creC510 | [64] |
| β3914 | RP4-2-Tc::Mu ∆dapA::(erm-pir) gyrA462 zei-298::Tn10 (KanR EmR TcR) | [65] |
| Plasmids | ||
| pNidKan | Suicide vector, pCVD442 derivative, KanR | [66] |
| pKD3 | Template for cat gene amplification (CmR) | [67] |
| pKD4 | Template for kan gene amplification (KanR) | [67] |
| Oligonucleotides | Sequence (5′-3′) a | Size (bp) |
|---|---|---|
| Tetracycline efflux pump tetB | ||
| 3′_int_tetB | TGAAGTGGTTCGGTTGGTTA | 319 |
| 5′_int_tetB | AATAGCACCCACACCGTTGC | |
| Tetracycline-resistance ribosomal protection protein tetM | ||
| 5′_int_tetM | TTCAACAGCCGTTTGCAGCA | 247 |
| 3′_int_tetM | TCTTTATAGTGGCGTACTGC | |
| aip56 toxin gene (pPHDP10 plasmid) | ||
| aip56_F | TCACGTTACAGGCTCTAGTG | 388 |
| aip56_R | GCATTCAACTGAACTGTCGG | |
| frpA piscibactin receptor gene (pPHDP70 plasmid) | ||
| frpA_5′ | GTGGTGTCACTTACAGCGAT | 229 |
| frpA_3′ | GAGACAGAAAACGTCACAGC | |
| parAB partition genes (pPHDPT3 plasmid) | ||
| parA_PP3_F | TCGTTCGTTTGGAGAATGGC | 582 |
| parB_PP3_R | GCCAATCGCAGGGTAGAACT | |
| T3SS gene vscJ (pPHDPT3 plasmid) | ||
| vscJ_PP3_F | GCGGAGACGAAATCAGATCG | 239 |
| vscJ_PP3_R | TCAGGCCGAACTTTACACCG | |
| T3SS gene vopD (pPHDPT3 plasmid) | ||
| vopD_PP3_F | GTAATACCTGCAAGCACACC | 322 |
| vopD_PP3_R | CAATCGGCGATCAAGCTAGA | |
| T3SS gene yopN (pPHDPT3 plasmid) | ||
| yopN_PP3_F | GCGCTCAACCACATCCTTGT | 431 |
| yopN_PP3_R | AAGCGCATGAGCTGGTTTCC | |
| T3SS gene vscQ (pPHDPT3 plasmid) | ||
| vscQ_F | GGCGTTGCTCAGTAGCCAAA | 363 |
| vscQ_R | GAGACCTGAAGCAGCACTTG | |
| T3SS gene vopD (pPHDPT3 plasmid) | ||
| vopD_F | GTAATACCTGCAAGCACACC | |
| vopD_R | TCACTATCGCTGCTTACACT | 185 |
| vcrD delection | ||
| vcrD_Xhol_1 | GCCTCGAGGAGAAGAGCCATCAGTACCT | 2041 |
| vcrD_BamHI_2 | GCGGATCCTTCTAGCGGTGTGGTGATGT | |
| vcrD_BamHI_3 | GCGGATCCTTAGCGCTTGACCCTTCTGT | 2027 |
| vcrD_NotI_4 | GCGCGGCCGCACTTGAACATCCGCTAAGCC | |
| vcrD_int_F | ATGCTTGCCGTGATGCTACT | 1943 |
| vcrD_int_R | GACACCACCAGTACAGGTTT | |
| Kanamycin resistance gene from pKD4 plasmid (kan) | ||
| kanR_pKD4_BamHI_5′ | GCGGATCCTAGAAAGCCAGTCCGCAGAA | 1190 |
| kanR_pKD4_BamHI_3′ | GCGGATCCGAAGCCCAACCTTTCATAGA | |
| Chloramphenicol resistance gene from pKD3 plasmid (cat) | ||
| cat_pKD3_BamHI_5′ | GCGGATCCTACCTGTGACGGAAGATCAC | 882 |
| cat_pKD3_BamHI_3′ | GCGGATCCGGAACTTCATTTAAATGGCG | |
Publisher’s Note: MDPI stays neutral with regard to jurisdictional claims in published maps and institutional affiliations. |
© 2022 by the authors. Licensee MDPI, Basel, Switzerland. This article is an open access article distributed under the terms and conditions of the Creative Commons Attribution (CC BY) license (https://creativecommons.org/licenses/by/4.0/).
Share and Cite
Abushattal, S.; Vences, A.; Osorio, C.R. A Highly Unstable and Elusive Plasmid That Encodes the Type III Secretion System Is Necessary for Full Virulence in the Marine Fish Pathogen Photobacterium damselae subsp. piscicida. Int. J. Mol. Sci. 2022, 23, 4729. https://doi.org/10.3390/ijms23094729
Abushattal S, Vences A, Osorio CR. A Highly Unstable and Elusive Plasmid That Encodes the Type III Secretion System Is Necessary for Full Virulence in the Marine Fish Pathogen Photobacterium damselae subsp. piscicida. International Journal of Molecular Sciences. 2022; 23(9):4729. https://doi.org/10.3390/ijms23094729
Chicago/Turabian StyleAbushattal, Saqr, Ana Vences, and Carlos R. Osorio. 2022. "A Highly Unstable and Elusive Plasmid That Encodes the Type III Secretion System Is Necessary for Full Virulence in the Marine Fish Pathogen Photobacterium damselae subsp. piscicida" International Journal of Molecular Sciences 23, no. 9: 4729. https://doi.org/10.3390/ijms23094729
APA StyleAbushattal, S., Vences, A., & Osorio, C. R. (2022). A Highly Unstable and Elusive Plasmid That Encodes the Type III Secretion System Is Necessary for Full Virulence in the Marine Fish Pathogen Photobacterium damselae subsp. piscicida. International Journal of Molecular Sciences, 23(9), 4729. https://doi.org/10.3390/ijms23094729







